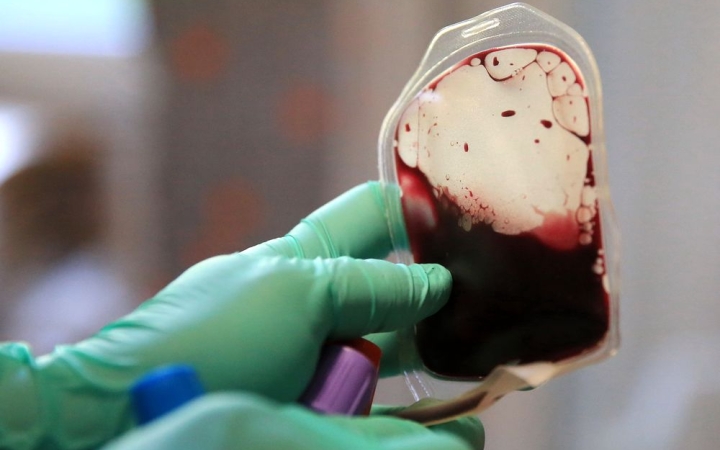
Véradás – ismét rendkívüli helyszíneken!

véradás
Újabb rendkívüli akció, hamarosan Mikulás véradás lesz
Már persze nem úgy, hogy csak a nagy szakállú ajándékosztókat csapolják! A helyszín az MMK, az időpont december 7., azaz jövő kedd – összeállításunkban a teljes decemberi tervezet mellett a jubiláló véradók listáját is közöljük!
Közeleg a véradók napja, egyértelmű siker az idei év
Dunaújvárosban is rendkívül nagy hagyománya van a véradásnak, amely az önkéntesek számában és az esemény megítélésében is megmutatkozik. A november 27-én esedékes véradók napja kapcsán Feth Katalin, és az önkormányzat képviselői osztották meg gondolataikat.
Sikeres volt a Halloween véradás – és már mutatom is a novemberi tervet (galériával)
Cicás csapolás, boszorkányos ügyesség, pokolbéli vígságok: 45 véradó, köztük 5 új donor vállalta a kihívásokat az MMK-ban rendezett, Halloweenre hangolt akción. És már itt a novemberi tervezet – meg egy bónusz infó a következő rendkívüli bevetésről! Mert vért adni: menő!
Boszorkányos csapolás: ezt az akciót Drakula gróf is nagyon irigyelné!
Újabb rendkívüli akciót, ezúttal Halloween véradást szerveznek – a boszorkányos csapolásra csütörtökön várnak az MMK-ba mindenkit, aki hiszi és vallja: vért adni menő! Véresen komoly felhívás a hajtás után!
Mind többen értik, érzik: vért adni menő!
Az elmúlt hónapok közösségi és/vagy intézményi alkalmai nyomán érzékelhetően nőtt a véradási hajlandóság, de az ősz beköszöntével szükség is van a növekvő vérigény kielégítésére – mint összeállításunkból kiderül, októberben is sok helyszínen várják a véradókat.
Két véradás közeleg rendkívüli helyszíneken!
Amint arról korábban már beszámoltunk, a retró véradás sikere is fényesen igazolja, hogy jó döntés közösségi eseményekkel kombinálni a véradás alkalmait – hamarosan két ilyen is lesz, máris írom, mikor és hol. Nem kérdés: vért adni menő!
Véradás – ismét rendkívüli helyszíneken!
A retró véradás hasábjainkon zengetett sikere is fényesen igazolja, hogy jó döntés közösségi eseményekkel kombinálni az alkalmakat: a jövő hónapban is lesznek ilyenek, ráadásul az iskolai véradások is megkezdődnek. Vért adsz? Menő!
Hatalmas sikert hozott a retró véradás (galériával)
A Dunaújváros 70 programsorozata jegyében szervezték az MMK-ban ma délután; sörfolyam, virsli és relikvia hegyek – és a legfontosabb: vérözön, hiszen 64 fő jelent meg a rendhagyó eseményen, és mentett meg három-három életet (még én is).
Küszöbön a retró véradás, kedden lesz a "csapolás"
A Dunaújváros 70 programsorozat keretében retró véradást szervez az MMK-ban a Magyar Vöröskereszt Dunaújvárosi Területi Szervezete kedden délután. Adj te is egy fángli vért és ments meg három életet!
Retró véradás is szerepel a kínálatban!
A Dunaújváros 70 programsorozat keretében készülnek egy különleges közösségi kezdeményezésre a véradáshoz kapcsolódva: retró eseményt szervez az MMK-ban a Magyar Vöröskereszt Dunaújvárosi Területi Szervezete. Vér, sör, virsli – mi kell még?
Minden cseppje kincs – várják a véradókat!
Az elmúlt hónap remekül sikerült a véradások szempontjából, de a nyár új kihívásokat tartogat; az igény nem csökken, de a szabadságolások miatt nehezebb a mozgósítás. Aki adott már, jól tudja: minden csepp vérrel segíthet!
DSTV: véradókat ünnepelt a Vöröskereszt
A véradók napjára emlékezett a DSTV összeállítása. Az alkalom apropóján Feth Katalin, a Magyar Vöröskereszt Dunaújvárosi Területi Szervezetének vezetője beszélt a véradás pótolhatatlan fontosságáról. Hangkép.